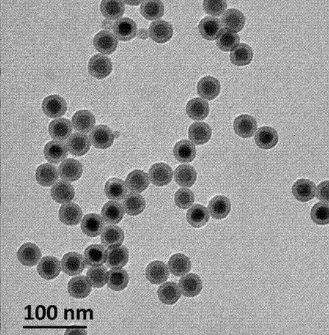

氨基化二氧化硅包覆核壳结构上转换纳米粒(808激发,绿光/蓝光)的应用
发布时间:2022-04-28 作者:zyl 分享到:
氨基化二氧化硅包覆核壳结构上转换纳米粒(808激发,绿光)
材料组成:氨基化二氧化硅包覆NaYF4,Yb,Tm@NaYF4,Yb,Nd,
激发波长808,发射波长365/450/470nm±15 nm,
表面配体-NH2,发绿光,分散在水中,
粒径50±10nm
相关产品:
氨基化二氧化硅包覆核壳结构上转换纳米粒(808激发,蓝光)
氨基化二氧化硅包覆核壳结构上转换纳米粒(808激发,绿光)
氨基化二氧化硅包覆核壳结构上转换纳米粒(980激发,蓝光)
氨基化二氧化硅包覆核壳结构上转换纳米粒(980激发,绿光)
氨基化二氧化硅包覆上转换纳米粒(980激发,蓝光)
氨基化二氧化硅包覆上转换纳米粒(980激发,绿光)
购买须知:
1.关于颜色
产品因不同产品的分子量不同,产品性状和颜色会有差别。
2.关于客服
如您的咨询没能及时回复,可能是当时咨询量过大或是系统故障。
我们将提供售后服务。
3.关于发货
我们的合作快递公司有顺丰、圆通、申通、韵达。
温馨提醒:仅供科研(zyl2022.4.28)




 齐岳微信公众号
齐岳微信公众号 官方微信
官方微信 库存查询
库存查询